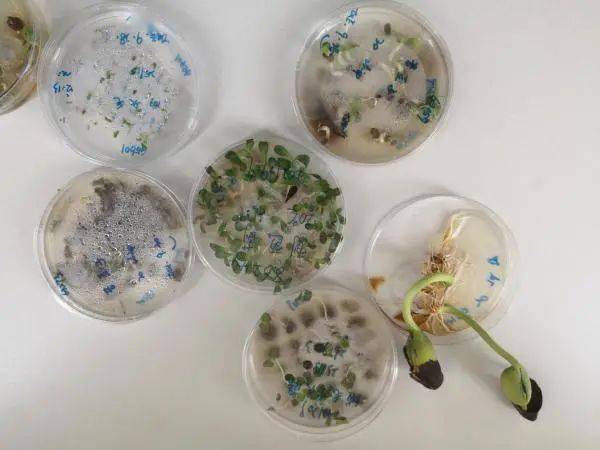
培养皿中刚刚发芽的种子

植物培养皿

植物,培养皿,隔绝,白色背景_高清图片_全景视觉
图片尺寸670x670
培养皿中的转基因植物
图片尺寸800x1200
在实验室培养皿中重新培育出整棵植物,然后通过切叶获取新生的细胞
图片尺寸960x1200
培养皿中生长的植物图片下载
图片尺寸800x533
培养皿中刚刚发芽的种子
图片尺寸600x450
皮氏培养皿,茅膏菜,栽培植物,人工授精,生物学
图片尺寸1200x844
烧杯,皮氏培养皿,桌子,植物群,彩色图片
图片尺寸1200x800
转基因的植物在皮氏培养皿中进行测试 .
图片尺寸682x1023
【优选好物】 一次性塑料培养皿圆形/方形分格平板细菌无菌植物细胞
图片尺寸800x800
转基因的植物在皮氏培养皿中进行测试 .
图片尺寸682x1023
测验,植物,培养皿,实验室
图片尺寸525x350
基因实验室培养皿上的年轻绿色植物
图片尺寸1200x800
生物科技,植物,培养皿,隔绝,黑色背景_高清图片_全景视觉
图片尺寸670x670
皮氏培养皿,植物,特写,化学课,生物学
图片尺寸1200x800
转基因的植物在皮氏培养皿中进行测试 .
图片尺寸1023x682
三个试管植物培养皿
图片尺寸1200x806
在实验室培养皿中进行植物实验
图片尺寸1200x800
培养皿的妙用
图片尺寸1080x1080
实验室,皮氏培养皿,植物群,餐具,垂直画幅
图片尺寸800x1200
在实验室培养皿中进行植物实验
图片尺寸1200x800